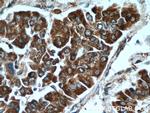
CCT3 Antibody in Immunohistochemistry (Paraffin) (IHC (P))

Search
Proteintech
CCT3 Polyclonal Antibody
{{$productOrderCtrl.translations['antibody.pdp.commerceCard.promotion.promotions']}}
{{$productOrderCtrl.translations['antibody.pdp.commerceCard.promotion.viewpromo']}}
{{$productOrderCtrl.translations['antibody.pdp.commerceCard.promotion.promocode']}}: {{promo.promoCode}} {{promo.promoTitle}} {{promo.promoDescription}}. {{$productOrderCtrl.translations['antibody.pdp.commerceCard.promotion.learnmore']}}
产品信息
10571-1-AP
种属反应
已发表种属
宿主/亚型
分类
类型
抗原
偶联物
形式
浓度
规格
纯化类型
保存液
内含物
保存条件
运输条件
产品详细信息
Immunogen sequence: EYKKGESQT DIEITREEDF TRILQMEEEY IQQLCEDIIQ LKPDVVITEK GISDLAQHYL MRANITAIRR VRKTDNNRIA RACGARIVSR PEELREDDVG TGAGLLEIKK IGDEYFTFIT DCKDPKACTI LLRGASKEIL SEVERNLQDA MQVCRNVLLD PQLVPGGGAS EMAVAHALTE KSKAMTGVEQ WPYRAVAQAL EVIPRTLIQN CGASTIRLLT SLRAKHTQEN CETWGVNGET GTLVDMKELG IWEPLAVKLQ TYKTAVETAV LLLRIDDIVS GHKKKGDDQS RQGGAPDAGQ E (246-545 aa encoded by BC006501)
靶标信息
The protein encoded by this gene is a molecular chaperone that is a member of the chaperonin containing TCP1 complex (CCT), also known as the TCP1 ring complex (TRiC). This complex consists of two identical stacked rings, each containing eight different proteins. Unfolded polypeptides enter the central cavity of the complex and are folded in an ATP-dependent manner. The complex folds various proteins, including actin and tubulin. Alternate transcriptional splice variants have been characterized for this gene. In addition, a pseudogene of this gene has been found on chromosome 8.
仅用于科研。不用于诊断过程。未经明确授权不得转售。
生物信息学
蛋白别名: CCT-gamma; Chaperonin containing T-complex polypeptide 1 subunit 3; chaperonin containing TCP1, subunit 3 (gamma); chaperonin subunit 3 (gamma); hTRiC5; Matricin; mTRiC-P5; OTTHUMP00000025735; proliferation-inducing gene 48; T-complex protein 1 subunit gamma; T-complex protein 1, gamma subunit; TCP-1-gamma; TCP1 (t-complex-1) ring complex, polypeptide 5; unnamed protein product
基因别名: AL024092; CCT-gamma; CCT3; CCTG; NEDSVH; PIG48; TCP-1-gamma; Tcp1-rs3; TriC-P5; TRIC5
UniProt ID: (Human) P49368, (Mouse) P80318, (Rat) Q6P502
Entrez Gene ID: (Human) 7203, (Mouse) 12462, (Rat) 295230